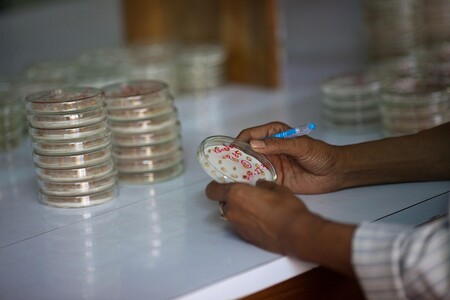
Genetické zdroje by měly být registrované. Ilustrační snímek Genetické zdroje by měly být registrované. Ilustrační snímek

Sněmovna podpořila úpravu pravidel pro užití genetických zdrojů
Kluby ODS, Pirátů a TOP 09 zablokovaly žádost vlády, aby dolní komora normu schválila zrychleně už v prvním čtení. Kabinet upozorňoval na to, že začlenění předpisů EU do tuzemské legislativy už má zpoždění a Česku by mohl hrozit postih.
Návrh upravuje pravidla pro zařazení sbírek genetických zdrojů do unijního registru, který spravuje Evropská komise. Zařazení do registru bude podle předlohy posuzovat ministerstvo životního prostředí. Kontrolovat dodržování podmínek pro přístup ke genetickým zdrojům by v Česku měla inspekce životního prostředí. Za porušení by mohla uložit pokuty až do 50.000 korun, peníze by plynuly do Státního fondu životního prostředí.
Část poslanců poukazovala na nejasnosti. František Vácha (TOP 09) soudí, že by podle něj mohla být nutná i registrace herbářů nebo sbírek motýlů či paroží, a to i soukromých. Ministr životního prostředí Richard Brabec (ANO) ale zdůraznil, že registrace by byla dobrovolná. Pokud by se ale uskutečnila, podmínky by se následně musely plnit.
Předlohu dostala Sněmovna od vlády už v minulém volebním období. Zůstala před druhým čtením a s volbami takzvaně spadla pod stůl. Evropská komise oznámila loni v říjnu ministerstvu pro životní prostředí, že s Českem zahájí řízení pro porušení povinnosti.
Kabinet očekává, že pokud by unijní soud pokutu Česku uložil, mohlo by jít o jednorázovou částku kolem 54 milionů korun a o dalších 270.000 korun denně až do zahrnutí evropského předpisu do českého právního řádu, stojí v důvodové zprávě. Nepřijetí zákona by navíc ztížilo výzkum a vývoj genetických zdrojů.
Genetickým zdrojem je podle předlohy jakýkoli "materiál rostlinného, živočišného nebo mikrobiálního původu, který obsahuje funkční jednotky dědičnosti a má pro člověka význam z hlediska dalšího využití".
reklama

Vláda schválila novelu, která má zamezit takzvanému lakování zboží nazeleno
Vláda znovu projedná novelu, která má zamezit tzv. lakování zboží nazeleno
Vláda schválila novelu, která má zamezit tzv. lakování zboží nazeleno